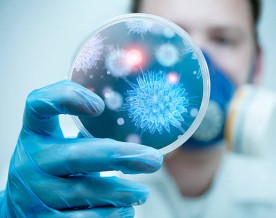

Experts urge standard treatment guidelines to streamline haemophilia care in India
Experts have called ...
- by PTI
- April 21, 2026
Indian cities' heat action plans must focus on high night-time temperatures, study says
A new analysis has f ...
- by PTI
- April 02, 2026
Detailed map of breast tissue may help explain why risk of cancer increases with age
Scientists have deve ...
- by PTI
- April 01, 2026
India among countries with highest total maternal deaths in 2023: Global analysis
India was among the ...
- by PTI
- March 31, 2026
Sale of fake obesity drugs driven by high prices, weight-loss desire prompts health concern: Lancet
Fake and falsified o ...
- by PTI
- March 18, 2026
Cuts to USAID could generate USD 7.5 bn additional costs for households in LMICs: Study
By 2050, cuts to US ...
- by PTI
- March 16, 2026
AI Set to Transform Pharma: Drug Development Could Speed Up and Boost Profits by 10%, Says Bernstein
Artificial intellige ...
- by PharmaNews Live Desk
- March 16, 2026
Modulating gut microbiome may help reverse ageing-related memory loss: Study
Remotely changing th ...
- by PTI
- March 13, 2026
India’s API Industry Set for Steady Expansion, CareEdge Projects 5–7% Growth Through FY28
India’s active pha ...
- by PharmaNews Live Desk
- March 05, 2026
India’s Organ Donation and Transplants Increase Fourfold, NOTTO Data Shows
India has recorded a ...
- by PharmaNews Live Desk
- February 23, 2026
Scientists find hidden synapse hotspots in the teen brain: Study
The scientists have ...
- by ANI
- January 19, 2026
India home to world's second largest diabetes population in 2024: Study
At 90 million, India ...
- by PTI
- January 17, 2026
Over 9,000 deaths due to respiratory diseases in Delhi, overall mortality rate goes up
The national capital ...
- by PTI
- January 17, 2026
India’s Healthcare M&A Activity Exceeds Rs 10,000 Crore in Q2 FY26, Led by Diagnostics and Specialty Care
India’s healthcare ...
- by Newsdesk
- January 15, 2026
44 pc Indian cities face chronic air pollution, only 4 pc covered under NCAP: Report
Nearly 44 per cent I ...
- by PTI
- January 11, 2026
Indian fertility experts advise caution on clinical use of new 'Non-Invasive' Embryo Genetic Test
As more couples in I ...
- by PTI
- January 05, 2026
Researchers raise concerns over antibiotic resistance linked to viruses on plastics
Viruses living on pl ...
- by PTI
- January 02, 2026
GST exemption boosts health insurance coverage, average sum insured jumps 31%: Report
The government's dec ...
- by ANI
- December 27, 2025
Emerging Lifestyle Patterns:Poor Sleep, Stress and Obesity Linked to Rising Breast Cancer Risk in India, ICMR Analysis Finds
A comprehensive inve ...
- by Newsdesk
- December 25, 2025
Cancer patients in India could rise to 2 million by 2040: MoS Jitendra Singh
India is third after ...
- by PTI
- December 18, 2025
No link between COVID-19 vaccines and sudden deaths in young adults: AIIMS
A year-long autopsy- ...
- by IANS
- December 15, 2025
Employee Medical Costs in India Set to Climb Sharply in 2026, Outpacing Global Growth
India is projected t ...
- by Newsdesk
- December 13, 2025
Screening for depression under govt primary healthcare may save up to Rs 482 billion: Study
Integrating universa ...
- by PTI
- December 11, 2025
Pakistan Faces Rapidly Escalating HIV Crisis as Cases Rise 200% in 15 Years
World Health Organiz ...
- by ANI
- December 03, 2025
India logged highest number of TB cases in 2024: WHO report
India accounted for ...
- by PTI
- November 13, 2025
80% Delhi-NCR households have one or more individuals struggling due to toxic air: Survey
Eight in 10 Delhi-NC ...
- by PTI
- November 11, 2025
Private Healthcare Dominates India’s Eye-Care Landscape as Public Services Lag Behind
A nationwide survey ...
- by Newsdesk
- November 11, 2025
Zero GST on health insurance plans sparks 38% surge in demand: Report
The government's mov ...
- by ANI
- October 30, 2025
Early metabolic risks emerging among professionals aged 30–40: MediBuddy
Digital healthcare p ...
- by Newsdesk
- October 30, 2025
Major Lapses Found in Domestic Drug Quality — 112 Batches Fail Nationwide, Himachal Pradesh Leads
The Central Drugs St ...
- by Newsdesk
- October 25, 2025
Vitamin B3 supplement may reduce your risk of skin cancer
A major shift is unf ...
- by PTI
- October 13, 2025
WHO monitoring situation amid deaths of children from cough syrup in MP
The World Health Org ...
- by ANI
- October 09, 2025
Ayurvedic cough syrups, home remedies are safe and effective for children: Experts
Amid concerns regard ...
- by PTI
- October 09, 2025
Experts say uterine cancer a growing health challenge, call for its inclusion in national NCDs
Uterine cancer repre ...
- by PTI
- October 07, 2025
Survey Reveals Serious Gaps in Brain Death Certification Training for Indian Medical Specialists
A recent study condu ...
- by Newsdesk
- October 06, 2025
Health insurance renewals in country touch all-time high persistency in FY26: Report
Health insurance ren ...
- by ANI
- September 30, 2025
Study finds what happens to your body when you eat too many ultra-processed foods
Ultra-processed food ...
- by ANI
- September 29, 2025
Spike in brain strokes among 40s and 50s, say doctors; stress timely diagnosis
Brain stroke cases a ...
- by PTI
- September 27, 2025
Indian hospitals to raise IT innovation spend by 25% in 3 years: Report
Indian hospitals are ...
- by PTI
- September 11, 2025
44% diabetics undiagnosed in 2023; underdiagnosis a challenge in poor countries: Study
About 44 per cent of ...
- by PTI
- September 09, 2025
Cardiovascular diseases cause one-third of all deaths in India: Report
Cardiovascular disea ...
- by PTI
- September 08, 2025
Gallstones in children on rise; doctors urge early detection, lifestyle changes
Once considered an a ...
- by PTI
- September 01, 2025
Scientists find simple tweaks that cut diabetes risk by 31%: Study
A Mediterranean-styl ...
- by ANI
- August 29, 2025
MediBuddy Study Finds 24% of Corporate Employees Pre-Diabetic
A striking new study ...
- by Newsdesk
- August 28, 2025
India recorded at least 84 heatstroke deaths in 2025 summer: Study
At least 84 heatstro ...
- by PTI
- August 24, 2025
Scientists identify how children develop immunity to bacterial infection, paving way for vaccine
Scientists have disc ...
- by PTI
- August 10, 2025
Data from India's ageing study suggests one-fifth of those aged 45 and above had diabetes in 2019
About a fifth of tho ...
- by PTI
- August 08, 2025
Corneal Blindness on rise among Indian youths, warn experts
Corneal blindness, o ...
- by PTI
- August 06, 2025
Delhi Residents Lean Towards Plant-Based Diets Over Weight-Loss Drugs, Survey Finds
A significant majori ...
- by Newsdesk
- August 06, 2025
Peptides: performance-boosting, anti-ageing drugs or dangerous snake oil?
For a growing number ...
- by PTI
- August 04, 2025
Age 50 might be inflexion point after which ageing accelerates, blood vessels vulnerable: Study
Analysing samples of ...
- by PTI
- August 03, 2025
How conspiracy theories about COVID's origins are hampering our ability to prevent the next pandemic
In late June, the Sc ...
- by PTI
- August 01, 2025
Researchers develop oral capsule to control gut bacteria via mobile app
Researchers have dev ...
- by PTI
- July 29, 2025
Study estimates over 9% of world's lands at high risk of animal-to-human infections
Over nine per cent o ...
- by PTI
- July 27, 2025
India recorded over 7000 suspected heatstroke cases, 14 deaths in March-June period: RTI
India reported 7,192 ...
- by PTI
- July 27, 2025
Study analyses intake of ultra-processed foods among South Asian countries
A study that analyse ...
- by PTI
- July 21, 2025
Global vaccine reserves helped avert 5.8 million infections, over 300,000 deaths since 2000: Study
Global stockpiles of ...
- by PTI
- July 14, 2025
Study estimates 13 pc of biomedical abstracts published in 2024 involved use of AI
At least 13 per cent ...
- by PTI
- July 06, 2025
Lancet study projects US foreign aid cuts could result in over 1.4 crore preventable deaths globally
Steep funding cuts t ...
- by PTI
- July 02, 2025
8.1% of urban corporate employees at elevated cardiac risk: MediBuddy Data
Healthcare company M ...
- by Newsdesk
- July 01, 2025
Study indicates incidence of rheumatoid arthritis increased 13 pc since 1990
Rheumatoid arthritis ...
- by PTI
- June 24, 2025
Study indicates incidence of rheumatoid arthritis increased 13 pc since 1990
Rheumatoid arthritis ...
- by PTI
- June 16, 2025
Physical, psychological therapies together more effective against back pain in long-term: Study
Combining physical a ...
- by PTI
- June 03, 2025
New Research Links Birth Control to Increased Stroke Risk: What Women Should Know
Millions of women re ...
- by Newsdesk
- June 01, 2025
Majority of Indians Fall Short on Fibre Intake, Women at Higher Risk, Reveals Nationwide Survey
As the world observe ...
- by Newsdesk
- May 29, 2025
Parkinson's disease four times more likely among people with autism, study suggests
People with autism c ...
- by PTI
- May 28, 2025
Why Hay Fever Feels Worse Than Ever in 2025—And What to Do If Your Go-To Remedies Aren’t Working
This year, hay fever ...
- by Newsdesk
- May 24, 2025
Nearly half of health insurance buyers in India cited rising medical expenses' as reason for purchasing insurance: Report
Nearly half (48 per ...
- by ANI
- May 20, 2025
Less or poor quality of sleep in babies could be risk factor of autism, study suggests
Babies who sleep les ...
- by PTI
- May 12, 2025
Half of 2020-born could face unprecedented exposure to climate extremes: Study
Over half the childr ...
- by PTI
- May 10, 2025
Study finds improving patient's ability to manage emotions could lower chronic pain
Improving one's abil ...
- by PTI
- May 07, 2025
Study finds abnormalities in brain common to insomnia, anxiety, depression
A new study has foun ...
- by PTI
- May 05, 2025
Study finds lab-created antibody effective in preventing severe respiratory illness in infants
A monoclonal antibod ...
- by PTI
- May 03, 2025
Anaemia in pregnancy linked to 47 per cent higher risk of heart condition in child at birth: UK Study
Being anaemic during ...
- by PTI
- April 25, 2025
India Tops Asia-Pacific in Healthcare PE Investments in 2024: Bain & Company Report
India has emerged as ...
- by ANI
- April 23, 2025
Blood pressure treatment could lower risk of dementia, clinical trial data suggests
Addressing high bloo ...
- by PTI
- April 22, 2025
TRENDS highlights vital role of scientific innovation in healthcare
As part of its US re ...
- by ANI
- April 21, 2025
Are artificial sweeteners okay for our health? Here's what current evidence says
Artificial sweetener ...
- by PTI
- April 19, 2025
Could CT scans be fuelling future rise in cancer cases, as new study suggests?
CT scans are a vital ...
- by PTI
- April 18, 2025
AIIMS Study Reveals Key Surgical Step Post-Chemotherapy Could Boost Survival in Ovarian Cancer Patients
A groundbreaking stu ...
- by PTI
- April 15, 2025
New research could help improve future whooping cough vaccines
Whooping cough, also ...
- by ANI
- April 07, 2025
Increased screen time found to increase depression risk in teen girls by disrupting sleep, study finds
Excessive screen tim ...
- by PTI
- April 05, 2025
Study links long-term antidepressant use to increased risk of sudden cardiac death
A new study presente ...
- by ANI
- April 02, 2025
Antibody-based therapy several notches closer to treat lethal mucormycosis: Study
Mucormycosis, a fung ...
- by ANI
- March 24, 2025
Bacteria-Based Cancer Therapies: A Revolutionary Approach Gaining Ground
The concept of using ...
- by Newsdesk
- March 21, 2025
Gene therapy for blood cancer shows 73 per cent response rate in clinical trials
An indigenously deve ...
- by PTI
- March 17, 2025
People living by river drains more prone to cancer: ICMR cites study
A study conducted in ...
- by PTI
- March 13, 2025
60% of gynaecology appointments sought by women aged 25-34 yrs: Health-tech platform’s survey
A survey on women pa ...
- by PTI
- March 11, 2025
India may have over 440 million overweight people by 2050: Lancet study
By 2050, India could ...
- by PTI
- March 04, 2025
Diet and Exercise: The Cornerstones of Fatty Liver Disease Management, Say Experts
New clinical guideli ...
- by Newsdesk
- March 03, 2025
Lifestyle and Environmental factors affect health and ageing more than genes: Study
A new study led by r ...
- by ANI
- February 23, 2025
Age group of 25-35 taking highest insurance claims: Policybazaar Report
The age group of 25- ...
- by ANI
- February 21, 2025
Five bn globally lack access to medical oxygen, poor nations most affected: Lancet report
Five billion people ...
- by PTI
- February 18, 2025
New study explains how antidepressants can protect against infections, sepsis
Antidepressants, suc ...
- by ANI
- February 17, 2025
Air pollution, extreme weather could increase risk of prolonged pregnancy: Study
Exposure to air poll ...
- by PTI
- February 13, 2025
Research reveals new insights into retinal thickness that may detect type 2 diabetes, dementia early
Researchers have con ...
- by ANI
- February 06, 2025
Economic Survey 2024-25 Highlights Need for Innovation in Pharma Sector
The Economic Survey ...
- by Newsdesk
- January 31, 2025
Indian healthcare sector most targeted by cyberattacks, followed by education: Report
The Indian healthcar ...
- by ANI
- January 27, 2025
Blood pressure management for 3 years could reduce risk of cognitive decline: Study
Aggressively managin ...
- by PTI
- January 24, 2025
Study finds majority of anaemia cases linked to causes other than iron deficiency
A major fraction of ...
- by PTI
- January 20, 2025
Indian Pharma Sector Faces Negative Volume Growth in Q3 FY25 but Retains Strong Margins: Report
The Indian pharmaceu ...
- by Newsdesk
- January 13, 2025
Digital Healthcare Trends Soar in 2024: MediBuddy Highlights India’s Changing Healthcare Landscape
MediBuddy, a leading ...
- by Newsdesk
- January 06, 2025
Which infectious disease is likely to be biggest emerging problem in 2025?
COVID emerged sudden ...
- by PTI
- December 26, 2024
Over 90% of Pollution-Related Deaths from Landscape Fires Occur in Low-Income Countries: Study
A recent study publi ...
- by Newsdesk
- November 28, 2024
Brain health could decline in men with heart disease risk a decade sooner than women, study finds
Men with risk factor ...
- by PTI
- November 27, 2024
India's pharma sector registers strong Q2 FY25 growth, driven by North America market: Report
Major pharmaceutical ...
- by ANI
- November 25, 2024
India’s Pharma Sector Faces Slowdown in Licensing and Tech Transfers: Report
India's pharmaceutic ...
- by Newsdesk
- November 22, 2024
Diagnosed Type 1 Diabetes Cases to Reach 3.166 Million by 2033: Report
The prevalence of di ...
- by Newsdesk
- November 19, 2024
India can save USD 10 bln annually by expanding insurance penetration: McKinsey report
India could potentia ...
- by ANI
- November 18, 2024
50-60 pc cancer cases detected in India annually are preventable, say oncologists
Around 1.4 million c ...
- by PTI
- November 10, 2024
Changes to gut composition linked with rheumatoid arthritis, study suggests
Changes in gut micro ...
- by PTI
- November 10, 2024
The Global TB Report 2024 by WHO acknowledged India's progress in tackling Tuberculosis
The World Health Org ...
- by ANI
- November 01, 2024
CDSCO Identifies 18 Drugs as Substandard, Including Four from Kerala’s State-Run Pharma Firm
In its September rep ...
- by Newsdesk
- October 25, 2024
Indian pharma firms trail global peers in R&D, innovation, and talent metrics: FAST India-IIFL Securities
Indian pharmaceutica ...
- by ANI
- October 22, 2024
Surge in Autoimmune Disorders Among Indians Post-COVID-19: Study Highlights Alarming 30% Rise in Antinuclear Antibody Positivity
Metropolis Healthcar ...
- by Newsdesk
- October 21, 2024
Indian Pharmaceutical Sector Set for 8-10% Revenue Growth This Fiscal
The Indian pharmaceu ...
- by Newsdesk
- September 20, 2024
Indian salt and sugar brands have microplastics: Toxics Link Study
All Indian salt and ...
- by PTI
- August 14, 2024
Women with PCOS at higher risk developing disordered eating, study finds
Women with hormonal ...
- by PTI
- August 10, 2024
Cannabis-derived CBG relieves anxiety, stress; may help improve memory: Study
Derived from the can ...
- by PTI
- August 10, 2024
Study Reveals Major Sources of Air Pollution in Northern India, Urges Targeted Interventions
New research led by ...
- by PharmaNews Live Desk
- May 01, 2024
Low-Fat Vegan Diet Benefits Type 1 Diabetes Patients: Study
A recent study done ...
- by Pooja Chaturvedi Sah
- April 01, 2024
Global cancer cases may rise 77% by 2050, deaths by 50%: Report
Over nine lakh peopl ...
- by TNN
- February 05, 2024
China's National Health Commission warns COVID-19 cases may rise during spring festival: Report
China's National Hea ...
- by ANI
- February 05, 2024
Bottled water contains upto 100 times more plastic than previously known: Study
The omnipresence of ...
- by Pooja Chaturvedi Sah
- January 09, 2024
Plant-based alternative to nicotine patches: Study finds
If your new year res ...
- by Pooja Chaturvedi Sah
- January 02, 2024
Programmable 3D printed wound dressing could improve treatment for burn, cancer patients: Study
The frequency of dre ...
- by Newsdesk
- June 08, 2023
Study finds how virtual blood vessel technology improves heart disease care
According to a new s ...
- by ANI
- June 06, 2023
Researchers target stem cells in human stomach to treat diabetes
A potential strategy ...
- by ANI
- May 26, 2023
How cancers in distant organs change liver function: Study
Researchers at Weill ...
- by ANI
- May 26, 2023
Death risk from liver disease twice as high in lower-income countries: Lancet study
The risk of death fo ...
- by PTI
- May 25, 2023
Over 800 million people globally may suffer back pain by 2050: Lancet
More than 800 millio ...
- by PTI
- May 23, 2023
Here’s How Ayurvedic Lifestyle Changes Can Help In Managing Stress
Stress is the body a ...
- by IANS
- May 22, 2023
Genetic risk factors identified for non-Alzheimer's dementia
Apart from dementia ...
- by IANS
- May 10, 2023
Optimal treatment for excessive daytime sleepiness: Research
The study shows that ...
- by ANI
- May 10, 2023
T cells can activate themselves to fight tumours: Research
When it comes to mot ...
- by ANI
- May 09, 2023
Research suggests how cancer cells may predict metastatic potential
Cancer cells that be ...
- by ANI
- May 08, 2023
New approach that help overcome treatment resistance in cancer: Research
The immune system's ...
- by ANI
- May 08, 2023
Nutrition has greater influence on gut microorganisms than defensins: Study
A multitude of varia ...
- by ANI
- May 08, 2023
Study uncovers details of evolution molecular interactions
Mathematicians have ...
- by PTI
- April 29, 2023
Scientists find novel way to reduce harmful side-effects of antibiotics
Scientists have foun ...
- by PTI
- April 17, 2023
Disrupted rhythms of rest contribute to symptoms of schizophrenia spectrum disorder: Study
Researchers from the ...
- by ANI
- April 14, 2023
Sugar molecule in blood can predict Alzheimer’s disease: Study
Early detection and ...
- by ANI
- April 13, 2023
Moderate exercise safe for people who suffer muscle pain from statins: Research
According to researc ...
- by ANI
- April 12, 2023
Childhood bronchitis, pneumonia linked with higher death risk from respiratory infection as adult: Lancet Study
People who had contr ...
- by Newsdesk
- March 10, 2023
Every year, 7,700 new cases of cancer are reported in Armenia - Reports Ministry of Health
Armenia: On World Ca ...
- by Newsdesk
- February 08, 2023
National Center of Oncology to host the third Armenian Cancer Congress
On February 4-5, 202 ...
- by Newsdesk
- February 04, 2023
Chimera molecule: Russian scientists develop compounds to fight cancer
Russian scientists t ...
- by Newsdesk
- January 28, 2023
Deaths from heart diseases went up during pandemic in certain people: Study
New York: The number ...
- by IANS
- January 27, 2023
Booster dose of Covishield offers best immune response: Lancet study
New Delhi: A booster ...
- by PTI
- January 25, 2023
Indian medicines saving Chinese lives amid Covid crisis: Report
Beijing: After nearl ...
- by ANI
- January 24, 2023